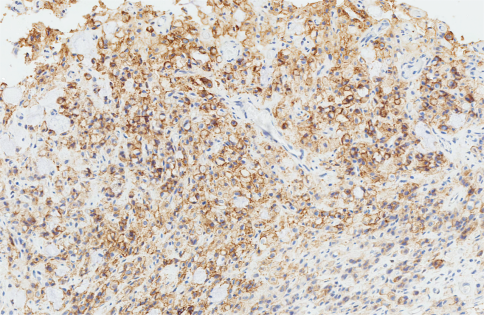

兩月前,國家藥監(jiān)局官網(wǎng)公示,安斯泰來(Astellas Pharma Europe B.V.)申報的進(jìn)口藥佐妥昔單抗(Zolbetuximab)在國內(nèi)獲批上市,佐妥昔單抗是目前全球首個且唯一獲批的CLDN18.2(Claudin18.2)靶向治療藥物。

該藥聯(lián)合含氟尿嘧啶類和鉑類藥物化療用于CLDN18.2陽性、人表皮生長因子受體2(HER2)陰性的局部晚期不可切除或轉(zhuǎn)移性胃或胃食管交界處(GEJ)腺癌患者的一線治療。目前已在中國、美國、歐洲、日本、韓國等多個國家和地區(qū)獲批上市。
CLDN18.2是一種細(xì)胞間緊密連接蛋白亞型,通常埋藏在正常胃上皮細(xì)胞的緊密連接中,難以被抗體識別;但在胃癌惡性轉(zhuǎn)化過程中,細(xì)胞極性和結(jié)構(gòu)的破壞導(dǎo)致CLDN18.2暴露于胃和胃食管交界處(G/GEJ)腺癌細(xì)胞的表面,使其更易被抗體接觸。

據(jù)諸多報道,CLDN18.2 被視為胃癌領(lǐng)域繼HER2后的新興高潛力靶點。研究數(shù)據(jù)顯示,約38%的胃癌患者表達(dá) CLDN18.2[1][2],這一比例顯著高于 HER2 陽性患者的 8.8%~12%[3][4] ;并且,CLDN18.2在胃癌、食管癌、胰腺癌、肺癌等多種腫瘤中皆呈現(xiàn)高表達(dá)。
針對CLDN18.2靶點的藥物研發(fā)具有巨大市場潛力和競爭價值。據(jù)不完全統(tǒng)計,全球有超 70 款 CLDN18.2 相關(guān)抗體新藥處于研發(fā)活躍狀態(tài),由中國企業(yè)研發(fā)的高達(dá) 58 款,占比 75% 以上。目前已有 7 款國產(chǎn)新藥進(jìn)展到 III 期臨床階段。

靶向CLDN18.2單克隆抗體佐妥昔單抗于2024年3月獲得日本厚生勞動省(MHLW)批準(zhǔn),成為全球首個被監(jiān)管機構(gòu)批準(zhǔn)的CLDN18.2靶向治療藥物。而后陸續(xù)在歐盟、韓國、美國、中國等地獲批。

佐妥昔單抗通過與腫瘤細(xì)胞表面 CLDN18.2 特異性結(jié)合,激活抗體依賴的細(xì)胞毒性作用(ADCC)和補體依賴的細(xì)胞毒性作用(CDC),從而誘導(dǎo)腫瘤細(xì)胞凋亡。
該藥物的兩項 III 期臨床試驗均達(dá)到積極結(jié)果:
SPOTLIGHT(NCT03504397) 研究結(jié)果顯示,接受聯(lián)合化療的中國受試者的 PFS (無進(jìn)展生存期)為 9.8個月,相較于安慰劑組的 6.5 個月顯著提升。OS (總生存期)方面,接受聯(lián)合化療的中國受試者達(dá) 16.7 個月,高于安慰劑組的 13.2 個月。

結(jié)論:在SPOTLIGHT研究的最終0S分析中,接受佐妥昔單抗聯(lián)合mFOLFOX6治療的CLDN18.2陽性、HER2陰性的局部晚期不可切除或轉(zhuǎn)移性胃或GEJ腺癌中國患者在PFS和0S方面顯示達(dá)到治療獲益,具有臨床意義。中國患者人群中的安全性和有效性結(jié)果與全球人群大體相似,未觀察到新的安全性信號。
GLOW (NCT03653507)研究結(jié)果顯示,接受聯(lián)合化療的中國受試者的 PFS(無進(jìn)展生存期) 為8.3 個月,相較于安慰劑組的 6.1 個月顯著提升。OS(總生存期) 方面,接受聯(lián)合化療的中國受試者達(dá) 14.5個月,高于安慰劑組的 10.7個月。

結(jié)論:在GLOW研究的最終0S分析中,接受佐妥昔單抗聯(lián)合CAPOX治療的CLDN18.2陽性、HER2陰性的局部晚期不可切除或轉(zhuǎn)移性胃或GEJ腺癌中國患者在PFS和0S方面顯示達(dá)到治療獲益,具有臨床意義。中國患者人群中的安全性和有效性結(jié)果與全球人群大體相似,未觀察到新的安全性信號。
免疫組化憑借其普及性、便捷性以及經(jīng)濟(jì)性等優(yōu)勢,成為檢測CLDN18.2表達(dá)較為成熟的方法?!?024CSCO胃癌診療指南》及《2024 ASCO GI》兩大指南皆推薦“抗Claudin18.2免疫組化檢測”——針對標(biāo)準(zhǔn)治療失敗的晚期或復(fù)發(fā)胃癌患者,為了尋找潛在的治療靶點,可進(jìn)行Claudin18.2、FGFR2、C-MET、NTRK基因等標(biāo)記物檢測?!癈SCO胃癌診療指南”相關(guān)推薦等級,由2023版的Ⅲ級推薦改為2024版Ⅱ級推薦。

》》判讀規(guī)則:
根據(jù)最新版NCCN胃癌指南(2024.V5版),Claudin18.2陽性由腫瘤細(xì)胞完整、基底外側(cè)或外側(cè)膜染色的強度,以及腫瘤細(xì)胞膜著色所占百分比兩個方面決定。
①判斷Claudin18.2蛋白在腫瘤細(xì)胞膜染色的強度,以及完整、基底外側(cè)或外側(cè)膜染色的癌細(xì)胞百分比。染色強度可分為0(細(xì)胞膜或細(xì)胞質(zhì)無反應(yīng))、1+(細(xì)胞膜或細(xì)胞質(zhì)弱反應(yīng)性)、2+(細(xì)胞膜或細(xì)胞質(zhì)中反應(yīng))、3+(細(xì)胞膜或細(xì)胞質(zhì)強反應(yīng)性)。
② Claudin18.2陽性:在≥75%的腫瘤細(xì)胞中,任何染色強度為2+或3+(總數(shù))的腫瘤。
● 陽性標(biāo)準(zhǔn):≥75%的腫瘤細(xì)胞顯示中等至強膜染色
● 陰性標(biāo)準(zhǔn):<75%的腫瘤細(xì)胞顯示中等至強膜染色
● 陽性對照:使用正常胃粘膜上皮細(xì)胞作為3+ 內(nèi)對照
》》注意事項:
1.建議多取活檢標(biāo)本,6-8塊為最佳,以避免假陰性結(jié)果。無論采集方法(活檢或切除)和部位(原發(fā)或轉(zhuǎn)移)如何,CLDN18.2陽性率相似,表明可以使用來自原發(fā)或轉(zhuǎn)移部位的樣本,通過免疫組化篩查CLDN18.2的表達(dá)狀態(tài);
2.標(biāo)本離體后應(yīng)盡快固定,建議在30分鐘內(nèi)處理,以確保固定效果。固定液要充分浸泡標(biāo)本,大標(biāo)本固定時間需12小時以上,小標(biāo)本也需充分固定;
3.切片厚度約4μm,過厚可能導(dǎo)致細(xì)胞層疊,影響判讀;過薄可能影響標(biāo)記部位的準(zhǔn)確性。合適的切片厚度有助于提高染色質(zhì)量和判讀的準(zhǔn)確性;
4.建議使用正常胃黏膜上皮作為內(nèi)對照,以驗證染色成功;
5.建議采用逐步法來評估CLDN18.2染色結(jié)果。第一步首先在HE切片上找到侵襲性癌區(qū)域,確保該區(qū)域至少包含50個癌細(xì)胞,才可進(jìn)行后續(xù)評估,同時需要排除壞死、組織碎片、擠壓偽影等非腫瘤區(qū)域,這些因素可能影響判讀的準(zhǔn)確性。第二步免疫組化切片觀察,包括特異性和強度的評估,主要關(guān)注中度至強陽性(2+或3+)的膜染色。使用正常胃粘膜上皮細(xì)胞作為3+內(nèi)對照,證實染色成功,并幫助識別陽性細(xì)胞,這有助于驗證染色結(jié)果的可靠性和準(zhǔn)確性。第三步計算陽性細(xì)胞百分比,計算2+和3+的腫瘤細(xì)胞占總腫瘤細(xì)胞的百分比。
迪安生物基于自主研發(fā)的CLDN18.2(Claudin18.2)抗體,能夠特異性識別癌癥組織中的CLDN18.2抗原,染色穩(wěn)定性強,背景干凈清晰,對精準(zhǔn)識別和治療CLDN18.2表達(dá)陽性的胃或食管胃結(jié)合部腺癌等患者具有重要臨床意義。
正常黏膜內(nèi)對照 胃腺癌
參考文獻(xiàn)
[1]種曉藝, 等. 中國腫瘤臨床. 2021, 48(8): 420-425.
[2]Shah MA, Shitara K, Ajani JA, et al. Nat Med. 2023 Aug;29(8)_2133-2141.
[3]黃丹, 李增山, 樊祥山, 等. 中國人40842例胃腺癌HER2多中心檢測結(jié)果分析[J] . 中華病理學(xué)雜志, 2018, 47(11) : 822-826.
[4]《胃癌HER2檢測指南(2016版)》專家組. 胃癌HER2檢測指南(2016版). 中華病理學(xué)雜志,2016,45(08):528-532.
*以上內(nèi)容僅作資訊整合解讀分享,不作為任何實際醫(yī)患診療建議參考;內(nèi)容如涉及版權(quán)問題請及時聯(lián)系刪除。